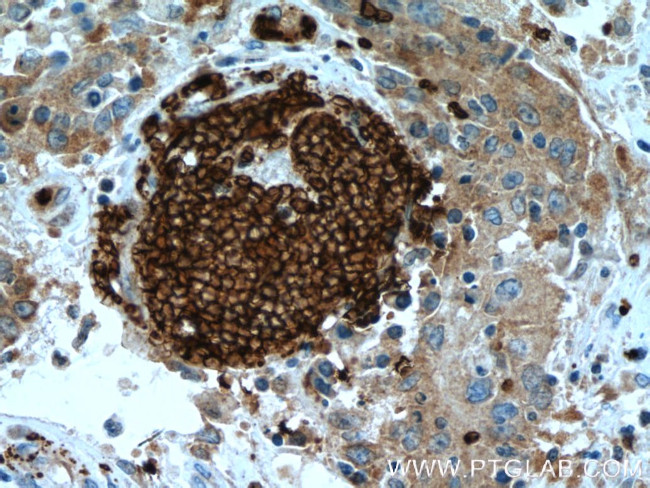
Glycophorin A Antibody in Immunohistochemistry (Paraffin) (IHC (P))
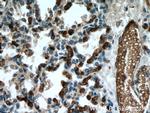
Glycophorin A Antibody in Immunohistochemistry (Paraffin) (IHC (P))
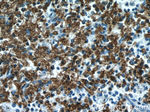
Glycophorin A Antibody in Immunohistochemistry (Paraffin) (IHC (P))

Search
Proteintech
Glycophorin A Polyclonal Antibody
{{$productOrderCtrl.translations['antibody.pdp.commerceCard.promotion.promotions']}}
{{$productOrderCtrl.translations['antibody.pdp.commerceCard.promotion.viewpromo']}}
{{$productOrderCtrl.translations['antibody.pdp.commerceCard.promotion.promocode']}}: {{promo.promoCode}} {{promo.promoTitle}} {{promo.promoDescription}}. {{$productOrderCtrl.translations['antibody.pdp.commerceCard.promotion.learnmore']}}
产品信息
15874-1-AP
种属反应
宿主/亚型
分类
类型
抗原
偶联物
形式
浓度
纯化类型
保存液
内含物
保存条件
运输条件
产品详细信息
Immunogen sequence: EVAMHTSTS SSVTKSYISS QTNDTHKRDT YAATPRAHEV SEISVRTVYP PEEETGERVQ LAHHFSEPEI TLIIFGVMAG VIGTILLISY GIRRLIKKSP SDVKPLPSPD TDVPLSSVEI ENPETSDQ (24-150 aa encoded by BC005319 )
靶标信息
Glycophorin A, also known as CD235a, is a 151 amino acid sialoglycoprotein expressed on the membrane of mature erythrocytes and erythroid progenitor cells, with approximately 500,000 copies per cell. The gene for glycophorin A is located on chromosome 4 and exists in two allelic forms, M and N, which differ by two amino acids: the M group has Ser1 and Gly5, while the N group has Leu1 and Glu5. These allelic variations define the blood group M and N specificities. Glycophorin A serves multiple functions, including providing a mucin-like barrier that minimizes aggregation between red blood cells in circulation, potentially preventing cell fusion. It also acts as a receptor for certain pathogens, including Sandei virus, parvovirus, and Hsa, a Streptococcus adhesin. Recent studies suggest that exposure to toxins can lead to mutations or loss of alleles, resulting in phenotypic changes. There is ongoing research correlating genotype and phenotype with predisposition to diseases such as cancer and heart disease, highlighting the importance of glycophorin A in both health and disease. Glycophorin A is a significant marker for studying erythrocyte-related functions and pathologies, as well as its role in pathogen interactions and disease predisposition.
仅用于科研。不用于诊断过程。未经明确授权不得转售。
篇参考文献 (0)
生物信息学
蛋白别名: CD235; CD235a; erythroid-lineage-specific membrane sialoglycoprotein; glycophorin A (MN blood group); glycophorin A, GPA; glycophorin Erik; glycophorin MiI; glycophorin MiV; glycophorin SAT; glycophorin Sta type C; Glycophorin-A; HGNC:4702; HGpMiX; HGpStaC; Mi.V glycoprotein; Mi.V glycoprotein (24 AA); MN sialoglycoprotein; PAS-2; recombinant glycophorin A-B Miltenberger-DR; Sialoglycoprotein alpha
基因别名: CD235a; GPA; GPErik; GPSAT; GYPA; HGpMiV; HGpMiXI; HGpSta(C); MN; MNS; PAS-2
UniProt ID: (Human) P02724
Entrez Gene ID: (Human) 2993